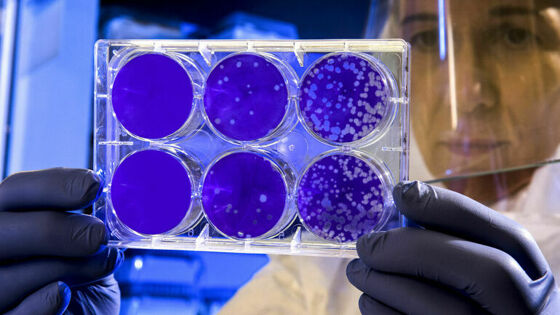

Вирусолог предостерег росссиян после снятия коронавирусных ограничений
Снятие противоэпидемических мер нельзя считать окончанием пандемии COVID-19. Об этом заявил в интервью радио Sputnik вирусолог Анатолий Альтштейн, комментируя решение Роспотребнадзора о приостановке действия противоэпидемических ограничений в стране.
Роспотребнадзор решил приостановить действие ряда ограничений, введенных ранее из-за пандемии коронавируса. В частности, отменен масочный режим, запрет на работу общепита в ночное время и ряд других мер.
«Ограничения сняли, потому что заболеваемость COVID-19 уменьшилась, она на очень невысоком уровне. Летальность тоже на очень невысоком уровне. Но ни в коем случае нельзя сказать, что пандемия завершилась, еще не все», — считает Альтштейн.
По его словам, в Америке и в Европе число заболевших более заразным вариантом штамма «омикрон» продолжает увеличиваться. Если так будет продолжаться, новая волна коронавирусной инфекции может прийти и в Россию.
Вирусолог призвал россиян не забывать про вакцинацию, несмотря на снятие ограничений. Надо быть готовыми на случай масштабного возвращения вируса в страну, предупредил он.